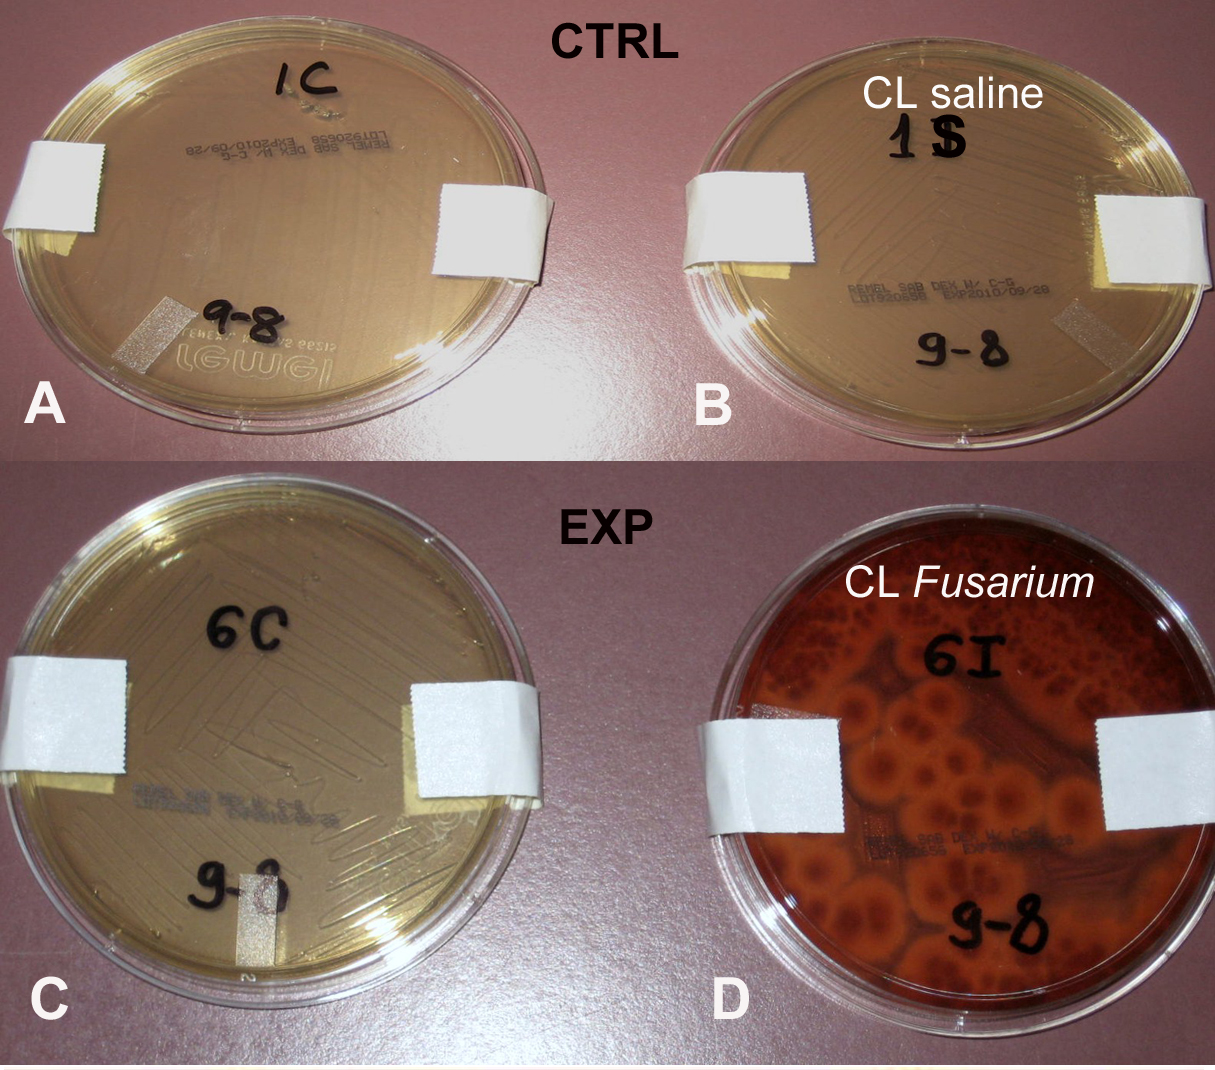

Figure 5. Corneas from rats fitted with contact lenses soaked in Fusarium suspension showed typical Fusarium solani growth when cultured on Sabouraud agar plates. One week post-infection corneas from rats fitted with contact lenses soaked
in control saline, and Fusarium suspension were removed, homogenized, and cultured on Sabouraud agar plates for 6 days. A, B: Both corneas of a representative control animal (CTRL), one from the eye fitted with a contact lens soaked in sterile saline
(CL saline), and the other from the contra-lateral eye, not fitted with a contact lens, showed no microbial growth. C, D: The cornea from a representative experimental animal (EXP) fitted with a Fusarium infected contact lens (CL Fusarium) showed typical Fusarium solani growth, while the contra-lateral eye showed no growth.